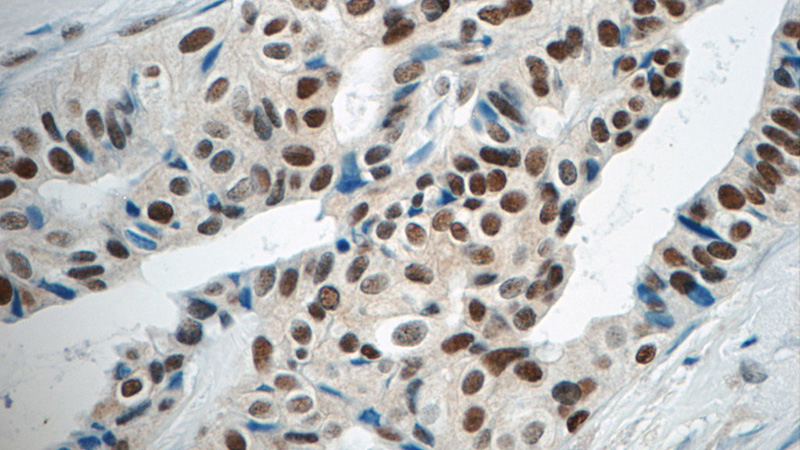
Immunohistochemistry of paraffin-embedded human breast cancer tissue slide using Catalog No:110881(GATA3 Antibody) at dilution of 1:50 (under 40x lens)

-
Product Name
GATA3 antibody
- Documents
-
Description
GATA3 Rabbit Polyclonal antibody. Positive WB detected in MCF7 cells, HeLa cells. Positive IHC detected in human breast cancer tissue, human colon cancer tissue. Observed molecular weight by Western-blot: 45-50 kDa
-
Tested applications
ELISA, WB, IHC
-
Species reactivity
Human,Mouse,Rat; other species not tested.
-
Alternative names
GATA binding factor 3 antibody; GATA binding protein 3 antibody; GATA3 antibody; HDR antibody
-
Isotype
Rabbit IgG
-
Preparation
This antibody was obtained by immunization of GATA3 recombinant protein (Accession Number: NM_002051). Purification method: Antigen affinity purified.
-
Clonality
Polyclonal
-
Formulation
PBS with 0.1% sodium azide and 50% glycerol pH 7.3.
-
Storage instructions
Store at -20℃. DO NOT ALIQUOT
-
Applications
Recommended Dilution:
WB: 1:200-1:2000
IHC: 1:20-1:200
-
Validations

MCF7 cells were subjected to SDS PAGE followed by western blot with Catalog No:110881(GATA3 antibody) at dilution of 1:500
Immunohistochemistry of paraffin-embedded human breast cancer tissue slide using Catalog No:110881(GATA3 Antibody) at dilution of 1:50 (under 40x lens)
-
Background
GATA3 is a transcriptional factor that binds to the enhancer elements of all 4 T-cell antigen receptor genes. GATA3 is highly expressed in naive, freshly activated cells and Th2 lineage cells and thought to be necessary and sufficient for Th2 cytokine gene expression. GATA3 and TBET interfer with each other to regulate gene expression. This is a rabbit polyclonal antibody raised agaist part of C-terminus of human GATA3.
-
References
- Froese N, Kattih B, Breitbart A. GATA6 promotes angiogenic function and survival in endothelial cells by suppression of autocrine transforming growth factor beta/activin receptor-like kinase 5 signaling. The Journal of biological chemistry. 286(7):5680-90. 2011.
- Adams JR, Xu K, Liu JC. Cooperation between Pik3ca and p53 mutations in mouse mammary tumor formation. Cancer research. 71(7):2706-17. 2011.
- Shen YM, Zhao Y, Zeng Y. Inhibition of Pim-1 kinase ameliorates dextran sodium sulfate-induced colitis in mice. Digestive diseases and sciences. 57(7):1822-31. 2012.
- Lu Y, Li L, Yan H, Su Q, Huang J, Fu C. Endothelial microparticles exert differential effects on functions of Th1 in patients with acute coronary syndrome. International journal of cardiology. 168(6):5396-404. 2013.
- Chen C, Xiang H, Peng YL, Peng J, Jiang SW. Mature miR-183, negatively regulated by transcription factor GATA3, promotes 3T3-L1 adipogenesis through inhibition of the canonical Wnt/β-catenin signaling pathway by targeting LRP6. Cellular signalling. 26(6):1155-65. 2014.
- Chen H, Fu T, Suh WK. CD4 T cells require ICOS-mediated PI3K signaling to increase T-Bet expression in the setting of anti-CTLA-4 therapy. Cancer immunology research. 2(2):167-76. 2014.
- Xu K, Usary J, Kousis PC. Lunatic fringe deficiency cooperates with the Met/Caveolin gene amplicon to induce basal-like breast cancer. Cancer cell. 21(5):626-41. 2012.
Related Products / Services
Please note: All products are "FOR RESEARCH USE ONLY AND ARE NOT INTENDED FOR DIAGNOSTIC OR THERAPEUTIC USE"
